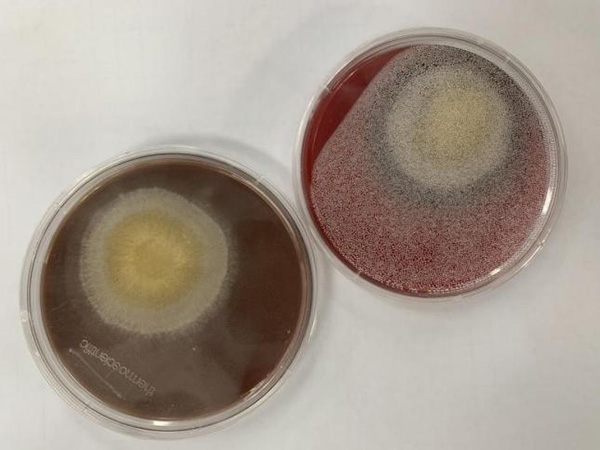

当构巢曲霉遇上“儿科天团”:感染内科 携手多学科打赢跨越514天的罕见真菌感染保卫战
2025-08-06 17:53:49
浏览次数:
近期,8岁男孩航航(化名)历经17个月、514天的艰难治疗,终于迎来了出院时刻。这场与罕见真菌(构巢曲霉)的漫长战斗,凭借北京儿童医院多学科团队的紧密协作以及感染内科医护团队无微不至的关怀,为航航铺就了一条充满希望的重生之路。
回溯到2024年1月29日,寒风呼啸,7岁的航航从外省紧急转诊至北京儿童医院急诊。那时的他,得病已半个月,因严重的中枢神经系统感染已陷入昏迷状态,体重仅34斤,骨瘦如柴的模样令人揪心。在外院因严重颅高压已进行侧脑室外引流术,头顶带着引流管的航航被第一时间收入感染内科病房,引流管中不断流出肉眼可见的白色脓液,生命危在旦夕。
48小时生死竞速:锁定罕见病原
感染内科团队医护人员在接收航航的瞬间就深知,每一秒都关乎着航航的生命,必须以最快速度找出致病根源。入院后立即启动病原学的检测,很快,不到36小时病原二代测序的结果回来了,紧接着细菌室也报告了一致的结果——“构巢曲霉”!入院不到48小时,已精准锁定了中枢神经系统感染的罪魁祸首。
构巢曲霉为曲霉菌的一种,分布于粮食、土壤和空气中,可引起人和动物感染致病。构巢曲霉是一种条件致病菌,其感染导致人类患病的情况极为罕见,多为有免疫缺陷基础疾病患者易感,如慢性肉芽肿病,已报道可导致肺、脑、骨、眼睛、鼻窦及皮肤等各部位感染及全身播散性感染。中枢神经系统构巢曲霉感染发病率极低,全世界报道非慢性肉芽肿病病人出现中枢神经系统构巢曲霉感染仅数例,北京儿童医院感染内科创科几十年来也仅收治过1例免疫功能正常儿童构巢曲霉感染的患儿。构巢曲霉感染早期病原诊断困难,治疗难度大,当临床确诊时病情往往已进展到一定程度,可能遗留严重的神经系统后遗症。
入院时,航航发病半月,已陷入昏迷,面对这一棘手状况,感染内科主任刘钢、带组组长朱亮副主任医师、主治医师肖海鹃、住院医师张永湛迅速讨论,制定治疗策略:采用伏立康唑联合两性霉素B脂质体静脉输注及两性霉素B脑室内注射联合抗真菌治疗,以最强有力的手段向病魔发起进攻,开启航航的闯关历程。
第一关:化解脑室梗阻突发危机
转眼间,2024年春节到来,本应是阖家团圆、充满欢乐的时刻,航航的病房却被紧张的氛围笼罩。大年初七清晨,航航突然呼吸急促、心率骤降,血氧饱和度急剧下降,甚至一度失去自主呼吸。张永湛住院医师及其他医护人员紧急展开抢救,待生命体征暂时平稳后,与影像中心联系,立即为其加做头颅MR检查。结果显示,双侧脑室室间孔堵塞,原有引流管仅能引流右侧脑室液,导致左侧脑室颅内压显著升高,危及生命,必须立即在左侧脑室置入引流管以缓解颅高压。
神经外科彭小娇主治医师接到通知后,迅速评估病情、制定手术方案,凭借精湛的医术,为航航紧急实施左侧脑室外引流术。当两根引流管成功置入的那一刻,仿佛为航航打开了两条“生命通道”,颅内压力得以有效控制,暂时脱离了生命危险。

然而,这仅仅是艰难征程的开始。航航接受了长达半年余的左右双侧脑室引流管同步引流、同时进行两性霉素B侧脑室内注射治疗。在此后的16个月里,由于长期携带两根侧脑室引流管,间断引流出脓性物质,且需要反复脑室内注射药物治疗,航航的引流管多次出现脱管、堵管、合并细菌感染等情况,导致颅内压升高、生命体征不平稳等问题。航航病情成为每周四神经外科全科人员与感染内科团队联合讨论的焦点。神经外科葛明主任医师、冀园琦主任医师及团队成员先后为航航进行了10余次手术。每一次手术,都是一次艰难的抉择;每一次成功,都凝聚着医生们的汗水与坚守,为航航筑起了坚固的生命防线。
第二关:持续发热与抗真菌方案突破
经过近2个月的全力治疗,航航脑室引流液中的脓液明显减少,脑脊液细胞学检查也有所改善,但他依旧反复发热,意识不清,头颅影像学显示颅内病灶未见明显好转,罕见感染难以控制的程度远超预期,整个脑脊液循环路径几乎都被真菌病灶堵塞,在儿童病例中极为罕见,药物治疗效果不佳,且因颅内感染部位分散无法手术切除病灶。这一状况让整个医疗团队一时陷入困境。

面对难题,医生们没有退缩。在经过查阅国内外大量资料,与药学专家深入沟通交流,反复权衡利弊、评估风险、制定应急预案,并征得家长知情同意后,一个大胆而艰难的决定诞生了——依据《颅内曲霉菌病中国专家共识》中推荐的伏立康唑血药浓度范围,将伏立康唑剂量逐渐增加至说明书常规推荐量的近两倍。这一决定需要巨大的勇气和专业底气,剂量增加后,患儿可能出现严重的肝功能损伤、胃肠道不适、视觉损害甚至头痛、惊厥等神经系统不良反应,医护人员时刻紧盯航航的每一个细微反应,不敢有丝毫懈怠。不负有心人,调整治疗方案后,航航双侧脑室开始再次间断引流出沉积的脓性物质,意识状态也有了显著改善。
2024年的五一劳动节前夕,一句微弱却清晰的“我要回家”从航航口中说出,瞬间让在场的医护人员和航航妈妈热泪盈眶,这是希望的曙光,是坚持的力量。
第三关:“大胆”用药迎来生命曙光
就在大家以为航航即将迎来康复时,命运又一次设下重重障碍。长期卧床的航航吞咽功能严重退化,引流物质的刺激引发频繁呕吐,进而造成呛咳、误吸,引发严重肺炎和呼吸衰竭。航航被紧急转入重症医学科(PICU),在气管插管呼吸机辅助通气下,经过PICU医护人员的精心照料,才艰难地闯过这一关,转回感染内科病房继续治疗。
然而,航航的病情并未就此稳定。复查后的头颅影像检查显示航航颅内病灶再次恶化。中枢神经系统曲霉感染整体诊治难度大,死亡率超过65%,治疗时间长,强化期抗真菌治疗通常为8~12周,若病情平稳,还需进入后续9~12个月的维持期治疗。航航感染的罕见的真菌构巢曲霉治疗上更是难上加难。此时,航航已接受联合强有力的抗真菌治疗半年多,家属心急如焚,整个医疗团队也倍感压力。
但是不放弃每一个患儿的坚定信念,感染内科郭凌云副主任医师带领医疗团队多次对病例进行复盘,大量查阅国内外文献,反复研读,参考成人颅内曲霉病诊治共识及儿童中应用艾沙康唑治疗其它曲霉菌感染的成功案例,试图找出解决方案。刘钢主任、郭凌云副主任医师及科室其他专家经过多次讨论,并征得家属同意后,慎重做出了又一个极具风险的决定——停用伏立康唑,改用艾沙康唑静点抗真菌治疗。
艾沙康唑属于超说明书用药,国内尚没有儿童适应症,且从未有过成功治疗儿童中枢神经系统构巢曲霉感染的案例。但为了挽救航航的生命,感染内科团队顶着巨大压力,经过院内流程批准后,果断调整方案。

幸运的是,这一次“大胆”的药物调整方案成为了治疗的转折点。此后数月,航航的意识逐渐恢复,能听懂简单交流、用手指数数,还能表达进食需求并经口少量进食,脸上的笑容也越来越多,颅内病变一点一点在减少,给家人和医护人员带来了无限希望。
人文微光:治疗室里的“音乐疗愈”
在近200次两性霉素B脑室内注射的治疗过程中,一个温暖的发现为航航的治疗增添了别样色彩。航航恢复意识后,张永湛住院医师偶然播放了一首《你不要担心》,原本因病痛略显疲惫的航航,听到音乐开头便露出了久违的笑容。与航航妈妈沟通后得知,航航从前在家就很喜欢这首歌,常常跟着哼唱。

自那以后,每次脑室内注射前的“音乐小课堂”成了固定仪式,也写在了航航脑室内注射的标准化操作流程中,肖海娟主治医师、李勤静主治医师、宁雪主治医师、张永湛住院医师、申烊阳住院医师等医生们准备好专用治疗室后、熟悉的旋律在治疗室响起,航航就会专注聆听,脸上洋溢着幸福的笑容。这短暂的时光,是医患之间无声的默契,是温暖的陪伴,更是支撑航航战胜病痛的强大力量。音乐,如同黑暗中的一束光,照亮了航航的康复之路,也拉近了医护与患儿之间的心灵距离。
多学科协作 共同谱写生命奇迹
时间来到了今年6月6日,航航成功接受了侧脑室-腹腔分流术。经过术后细致观察和全面评估,6月26日,这个曾经与死神多次擦肩而过的孩子终于迎来了出院的日子。514个日夜,是感染内科、神经外科、影像科、药学部、重症医学科、营养科、康复科、内分泌科、心内科等多学科团队“以患儿为中心”的坚守,是父母不离不弃的陪伴,是医学智慧与人文关怀共同谱写的生命奇迹。


航航的康复,充分彰显了北京儿童医院作为“国家队”的硬核实力。从罕见病原的快速精准诊断,到突破常规的治疗决策;从多学科的无缝协作,到对患儿身心需求的贴心关怀,每一个环节都诠释着“生命至上”的医者初心。这场与构巢曲霉的持久战,不仅是医学技术的胜利,更是“医者仁心”的生动写照。在北京儿童医院,每一个生命都值得倾尽全力守护,每一份坚持都能点亮生命的希望之光。
上一篇: 新生儿中心举办世界母乳喂养周系列活动









.jpg)

.jpg)




